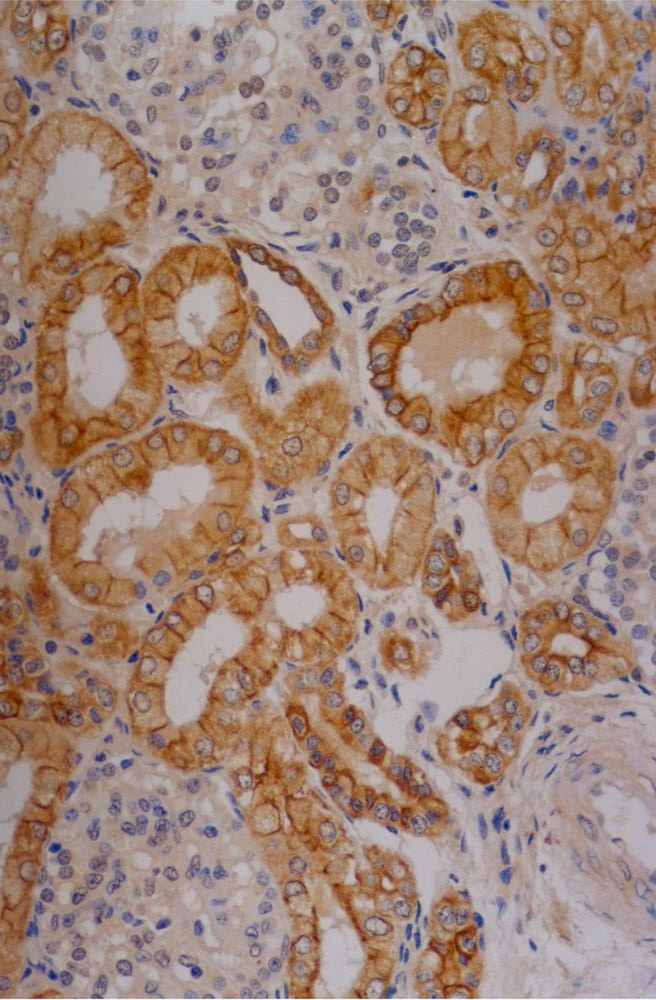
Cytokeratin 18 antibody [C-04] (FITC)

相关产品推荐更多 >
万千商家帮你免费找货
0 人在求购买到急需产品
- 详细信息
- 文献和实验
- 技术资料
- 免疫原:
Cytoskeleton preparation of epidermal carcinoma cell line A431.
- 亚型:
IgG1
- 形态:
Liquid
- 保存条件:
Store as concentrated solution. Centrifuge briefly prior to opening vial. Store at 4ºC. DO NOT FREEZE. Protect from light.
- 克隆性:
Monoclonal
- 标记物:
FITC
- 适应物种:
Human, Mouse, Rat
- 保质期:
12 months from the shipping date of the product.
- 抗原来源:
Human
- 目录编号:
GTX80207
- 级别:
Primary Antibodies
- 库存:
Available
- 供应商:
GeneTex
- 宿主:
Mouse
- 应用范围:
IHC-P, FACS
- 浓度:
0.1 mg/ml (Please refer to the vial label for the specific concentration.)
- 靶点:
Cytokeratin 18
- 抗体英文名:
Cytokeratin 18 antibody [C-04] (FITC)
- 抗体名:
Cytokeratin 18 抗体 [C-04] (FITC)
- 规格:
100 μg
Immunohistochemistry staining of human kidney (paraffin-embedded sections) with anti-Cytokeratin 18 (C-04).
Intracellular flow cytometry analysis of cytokeratin expression in HeLa human cervix carcinoma cell line using anti-Cytokeratin 18 (C-04) FITC.Overlay with Isotype mouse IgG1 control (PPV-06).
Immunohistochemistry staining of human colon (paraffin-embedded sections) with anti-Cytokeratin 18 (C-04).
风险提示:丁香通仅作为第三方平台,为商家信息发布提供平台空间。用户咨询产品时请注意保护个人信息及财产安全,合理判断,谨慎选购商品,商家和用户对交易行为负责。对于医疗器械类产品,请先查证核实企业经营资质和医疗器械产品注册证情况。
文献和实验De Matteis R et al., Stem Cells 2009 (PMID:19688834)
当FITC在碱性溶液中与抗体蛋白反应时,主要是蛋白质上赖氨酸的r氨基与荧光素的硫碳胺键(thiocarbmide)结合,形成FITC-蛋白质结合物,即荧光抗体或荧光结合物。一个IgG分子中有86个赖氨酸残基,一般最多能结合15~20个,一个IgG分子可结合2~8个分子的FITC,其反应式如下FITC-N=C=S + N-H2-蛋白质 → FITC-NS-C-N-H2-蛋白质常用Marsshall(1958)法标记荧光抗体,也可以根据条件采用Chadwick等标记法或Clark
. When Biotinylating an antibody, you can test the antibody by Flow Cytometry. 6. F/P Ratio: a) Dilute an aliquot of FITC-Ig complex with buffer so that the Absorbance at 280nm (A280) is less than 2.0 b) Determine and record A280 and A492. c) Calculate
8.0) in clean 16x125mm polypropylene test tube. If needed, adjust pH to 8.0 using 0.5M carbonate buffer. 2. Prepare fresh, 1mg/mL of either NHS-FITC in DMSO or 1mg/mL NHS-LC-Biotin in DH2O. If FITC coupling, add 75uL of FITC/DMSO solution to Antibody
技术资料暂无技术资料 索取技术资料

![E-Cadherin antibody [DECMA-1]](https://img1.dxycdn.com/2022/0328/561/7603821484379700453-14.jpg!wh200)


